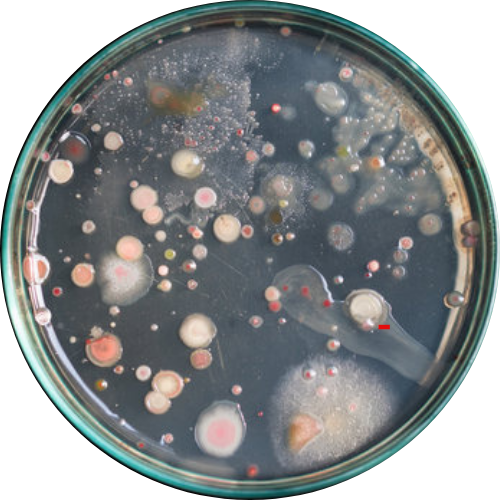

Fluoride
Enjoy Cleaner, Fresher Tasting Water - Instantly

See the Difference From Day 1

Why You Need Purafion
Say Goodbye to Hidden Nasties!
Protect Your Home Today with Purafion.
REASONS TO FILTER TAP WATER









HOW DOES IT WORK?
Introducing PURECLEAR 7 Stage Filtration








Loved By Thousands of Aussie Families!
Will it Fit My Tap?








Order Today and Get 50% Off Our Sale Price!
+ $100 Worth of Free Gifts Included!
WHAT'S INCLUDED:

BONUS TODAY:




Buy More, Save More!
1 x Purafion
Save 50% Off

Purafion Filter Bundle
Save $130 Off

Purafion Home Bundle
Total $230 Off



















